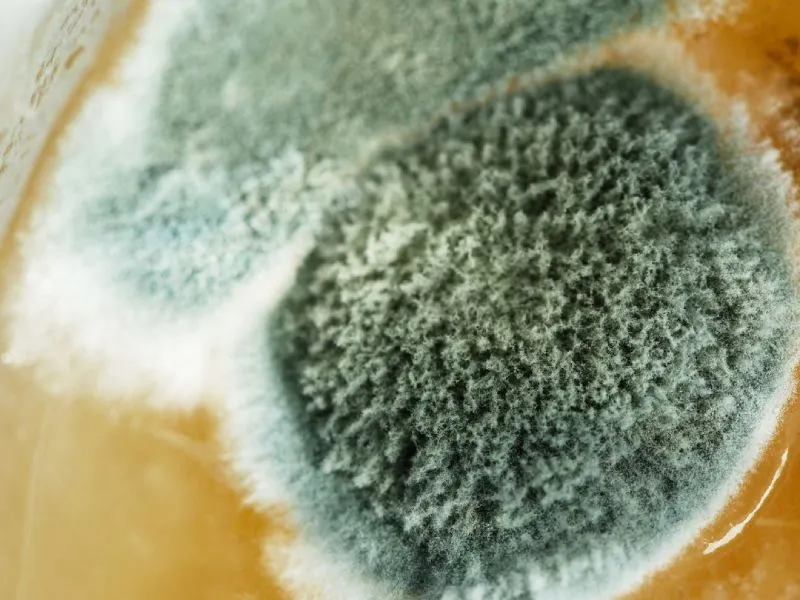

Signs You May Need Mold Remediation in New Port Richey, FL
Mold problems do not always start with obvious growth. In many cases, the first signs are musty odors, recent water damage, or areas that feel damp over time. In New Port Richey, FL, humidity and moisture can quickly lead to mold forming in hidden spaces like behind walls or under flooring.
Waiting too long allows the problem to spread and cause more damage. Taking action early helps limit the impact, protect building materials, and prevent more expensive repairs down the line.
How We Handle Mold Removal & Remediation
At Anclote Restoration, we approach mold removal with a focus on identifying the source, containing the affected areas, and removing contamination safely using proven methods. Our process includes addressing moisture issues, cleaning impacted surfaces, and ensuring the space is properly dried to prevent future growth. Every step is handled carefully to restore a clean, stable environment and reduce the risk of mold returning.
What Causes Mold Growth in New Port Richey, FL Homes?
Mold growth in New Port Richey, FL is often triggered by excess moisture, high humidity, and water damage from leaks, storms, or plumbing issues. Florida’s climate creates the perfect environment for mold to spread quickly, especially in areas like bathrooms, attics, crawl spaces, and behind walls where moisture can build up unnoticed.
Common causes include roof leaks, AC condensation, poor ventilation, and past water damage that wasn’t fully dried. Once moisture is present, mold can begin growing within 24 to 48 hours. Addressing the source early and scheduling professional mold removal is key to preventing more serious structural damage and indoor air concerns.
Signs You Need Professional Mold Removal in New Port Richey, FL
Mold isn’t always obvious, and by the time you see it, the problem is usually bigger than it looks. Warning signs include musty odors, visible discoloration on walls or ceilings, peeling paint, and areas that feel damp or humid. In some cases, mold may be hidden behind drywall, under flooring, or inside HVAC systems.
If you’ve recently had water damage or notice ongoing moisture issues, it’s smart to act quickly. Professional mold removal services help locate hidden growth, remove contamination safely, and restore a clean, stable environment. Ignoring the issue can lead to more costly repairs and ongoing problems over time.